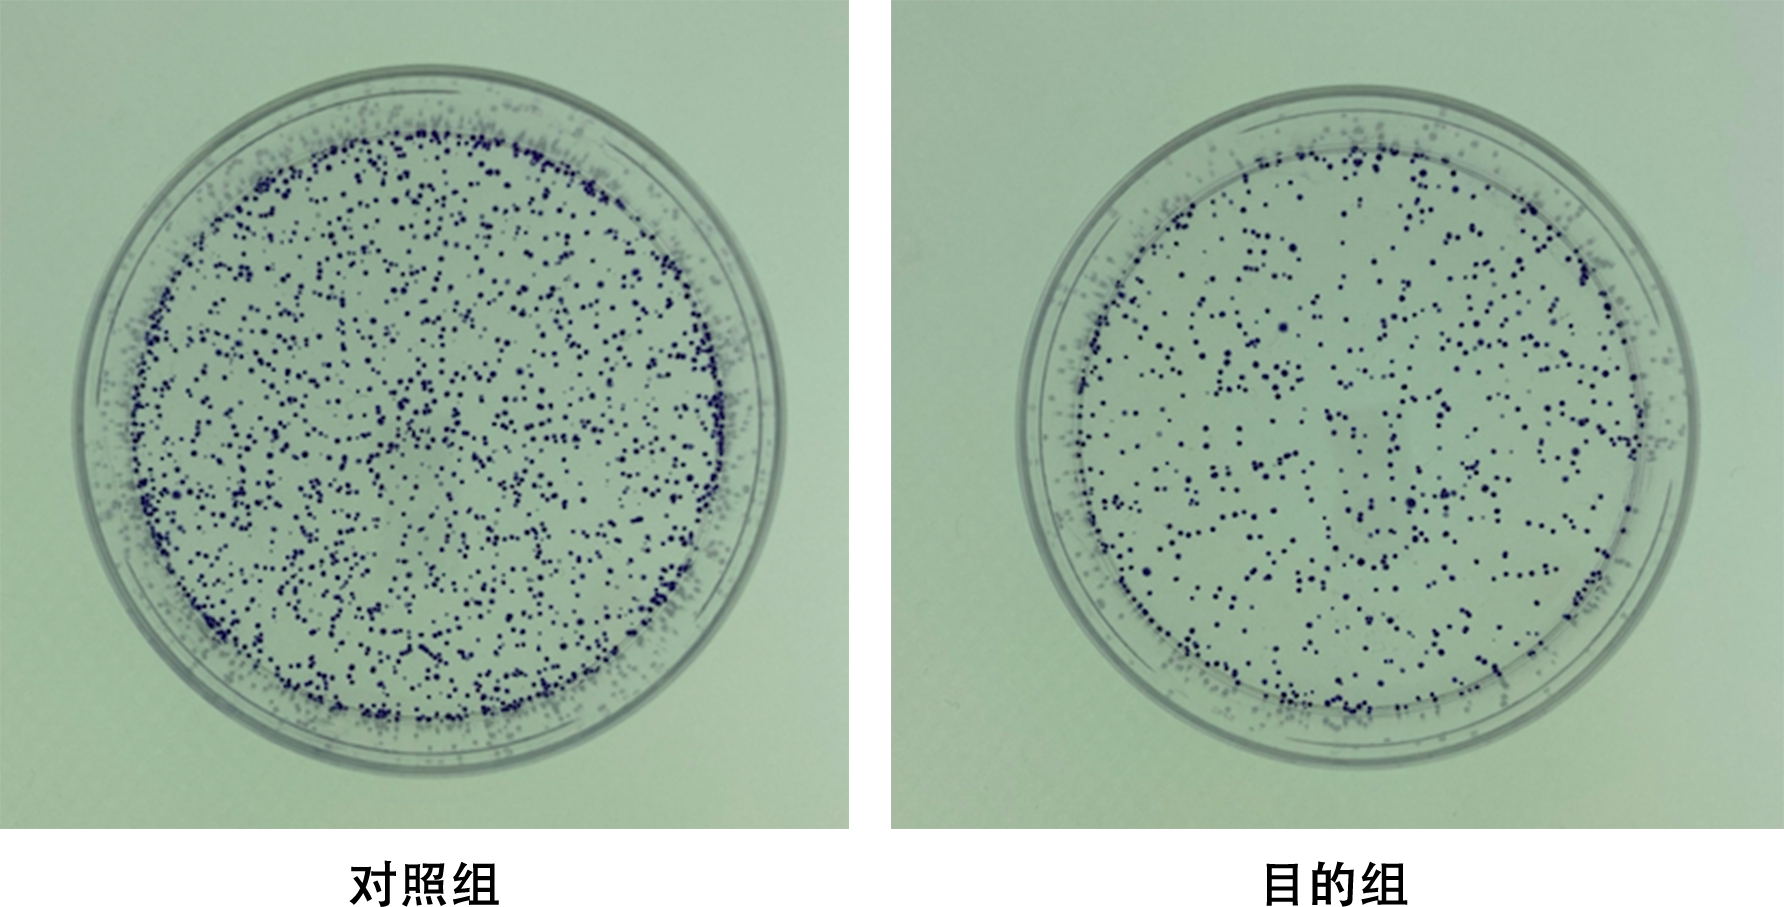

首页 > 细胞实验
首页 > 细胞实验
细胞功能检测
细胞功能检测是评估细胞生理状态、行为特征及对外界刺激反应的重要技术手段,广泛应用于基础研究、药物开发和临床诊断等领域。以下从检测类型、技术原理及应用场景进行系统介绍:
一、核心检测技术分类
MTT/CCK-8法:通过检测活细胞线粒体脱氢酶活性,将四唑盐(如MTT)或WST-8还原为有色甲瓒,吸光度值与活细胞数量成正比。
Transwell实验:模拟细胞穿过基质膜的能力,评估迁移(无基质胶)或侵袭(含基质胶)活性。
划痕实验:通过人工划痕观察细胞迁移修复速度,操作简便但需控制划痕一致性。
流式细胞检测:Annexin V-FITC/PI双染区分早期凋亡、晚期凋亡及坏死细胞。
Caspase活性检测:特异性底物法检测凋亡关键蛋白酶活性。
实验流程:

结果示例:

细胞周期(cell cycle)是指能持续分裂的真核细胞从一次有丝分裂完成到下一次分裂结束的循环过程,一般分为间期和分裂期两个阶段。其中分裂间期持续时间远长于分裂期,在一个正常的细胞周期中,间期持续时间约占整个细胞周期的90%左右。在间期中,细胞会生长、复制染色体,并为分裂做准备。然后,细胞离开间期,经历有丝分裂,并完成其分裂,由此产生两个子细胞。癌变的细胞以及特定阶段的胚胎细胞常常有异常的分裂周期。
克隆形成实验是测定细胞存活率和考察单个细胞增殖能力的有效方法之一。单个细胞在体外连续6代以上,其后代所组成的细胞群称为克隆或集落,这时每个克隆大小在0.3-1.0mm,含有50个以上的细胞,通过计数克隆形成率,可对单个细胞的增殖潜力做定量分析,常用的手段有两个:平板克隆形成实验和软琼脂克隆形成实验。
服务流程